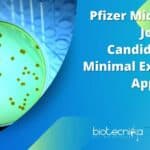
Pfizer Microbiology Job For MSc Candidates With Minimal Experience, Apply Online Pfizer Microbiology Job For
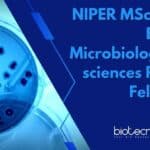
NIPER MSc Biotech, Biochem, Microbiology & Life sciences Research Fellow Post NIPER MSc Biotech

Home Search
biology - search results
If you're not happy with the results, please do another search
Colgate-Palmolive Opportunity For Biological Sciences & Microbiology Candidates
Colgate-Palmolive Microbiology Vacancy For MSc Candidates, Apply Online
Colgate-Palmolive Microbiology Vacancy For MSc Candidates, Apply Online. MSc Microbiology Jobs. Interested and eligible applicants can check...
Amity University AIMMSCR Hiring MSc & MTech Biotech, Biochem, Zoology & Microbiology For PA...
Amity University AIMMSCR Hiring MSc & MTech Biotech, Biochem, Zoology & Microbiology For PA Post
Amity University AIMMSCR Hiring MSc & MTech Biotech, Biochem, Zoology...
CSIR-CCMB Project Vacancies For Biotech, Biochem, Life Sciences, Microbiology Candidates, Apply Online
CSIR-CCMB Project Vacancies For Biotech, Biochem, Life Sciences, Microbiology Candidates, Apply Online
CSIR-CCMB Project Vacancies For Biotech, Biochem, Life Sciences, Microbiology Candidates, Apply Online. Project...
Pfizer Microbiology Job For MSc Candidates With Minimal Experience, Apply Online
Pfizer Microbiology Job For MSc Candidates With Minimal Experience, Apply Online
Pfizer Microbiology Job For MSc Candidates With Minimal Experience, Apply Online. Pfizer is hiring...
ACTREC JRF Job For Biology, Biotech, Biochem, Zoology & Life Sciences
ACTREC JRF Job 2023 For Biology, Biotech, Biochem, Zoology & Life Sciences
ACTREC JRF Job 2023 For Biology, Biotech, Biochem, Zoology & Life Sciences. MSc...
NIAB MSc, PhD Biotech, Biochem, Microbiology & Life Sciences Project Jobs Available, Apply Online
NIAB Project Research Openings For MSc, PhD Life Sciences - Apply Online
NIAB Project Research Openings For MSc, PhD Life Sciences - Apply Online. National...
ICAR-NRRI JRF Job For Biotech, Botany & Microbiology
ICAR-NRRI JRF Job For Biotech, Botany & Microbiology
ICAR-NRRI JRF Job For Biotech, Botany & Microbiology. MSc Biotech, Botany and Microbiology JRF Job. Interested and...
IISER Kolkata Project Jobs For MSc Biotech, Zoology & Microbiology
IISER Kolkata Project Jobs For MSc Biotech, Zoology & Microbiology
IISER Kolkata Project Jobs For MSc Biotech, Zoology & Microbiology. MSc project assistant jobs. MSc...
Importance + List of Molecular Biology Techniques every Life Science Graduate & Post Graduate...
Molecular biology techniques play a crucial role in modern biological research. As a graduate or postgraduate student, being proficient in these techniques can greatly...
NIAB Bioinformatics, Computational Biology & Life Sciences Project Jobs – Apply Online
NIAB Bioinformatics, Computational Biology & Life Sciences Project Jobs - Apply Online
NIAB Bioinformatics, Computational Biology & Life Sciences Project Jobs - Apply Online. National...
NIPER MSc Biotech, Biochem, Microbiology & Life sciences Research Fellow Post
NIPER MSc Biotech, Biochem, Microbiology & Life sciences Research Fellow Post
NIPER MSc Biotech, Biochem, Microbiology & Life sciences Research Fellow Post. NIPER Jobs. JRF...
TIFR Mumbai MSc Biology & BTech Biotech Research Fellow Recruitment
TIFR Mumbai MSc Biology & BTech Biotech Research Fellow Recruitment
TIFR Mumbai MSc Biology & BTech Biotech Research Fellow Recruitment. TIFR Mumbai Jobs 2023. Biotechnology...
IISER Pune Summer Student Programme 2023 – Apply Online For Biology Projects
IISER Pune Summer Student Programme 2023 - Apply Online For Biology Projects
IISER Pune Summer Student Programme 2023 - Apply Online For Biology Projects. IISER...
Vallabhbhai Patel Chest Institute Biotech & Microbiology Research Fellow Recruitment
VPCI Biotech SRF Job - MSc Microbiology Candidates Can Apply
VPCI Biotech SRF Job - MSc Microbiology Candidates Can Apply. MSc Microbiology and Biotech SRF...
ICMR-NIIH MSc SRF Job – Biotech, Biochem, Biology, Bioinformatics, Microbio Apply Online
ICMR-NIIH MSc SRF Job - Biotech, Biochem, Biology, Bioinformatics, Microbio Apply Online
ICMR-NIIH MSc SRF Job - Biotech, Biochem, Biology, Bioinformatics, Microbio Apply Online. MSc...